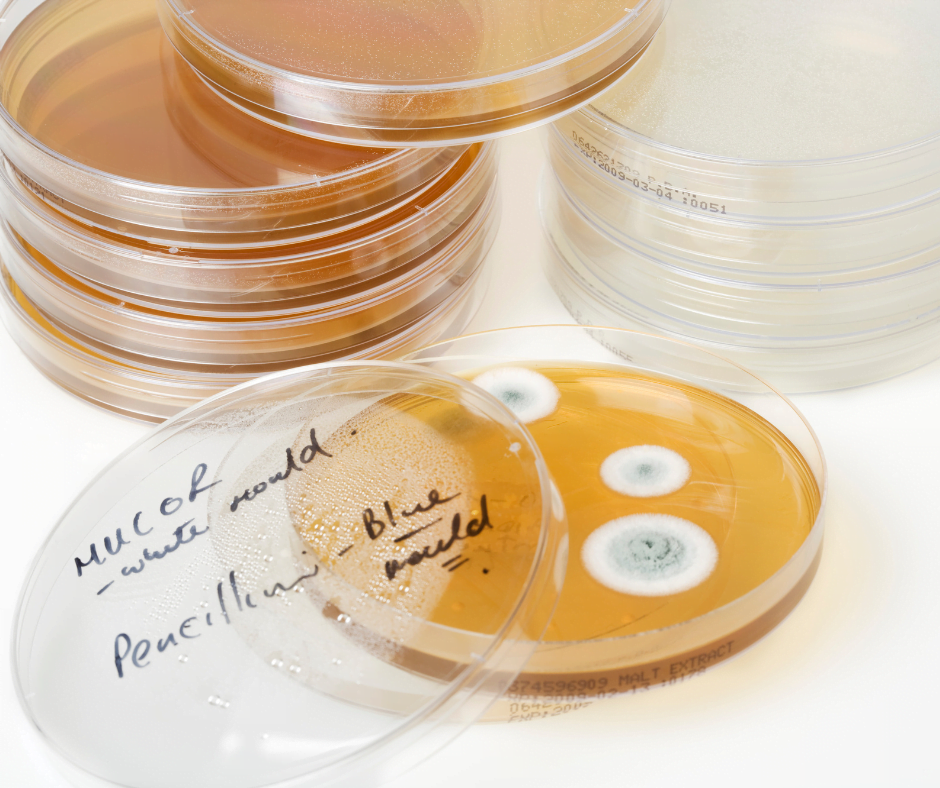

Eradicating Mould With Huwa-San
Let’s explore how the presence of mould in homes affects our health, and what the best methods are to combat mould effectively.
For any queries and questions about this post, please contact us.
Blog Archive
What Is Mould?
Mould is one of the structures certain fungi can form. The dust-like, coloured appearance of mould is due to the formation of spores containing fungal secondary metabolites. The most commonly known fungal secondary metabolite is penicillin, discovered by Alexander Fleming in 1928. Most of us are familiar with mould, it’s the black stuff you see on shower room tiles and damp patches on walls. Moulds are ubiquitous and are a common component of household dust.
Mould, in a home, is found in moist, steamy places like bathrooms, kitchens, cluttered storage areas, and also in bedrooms. Basically, anywhere there is moisture and poor ventilation.
How Does Mould Affect Your Health?
Not only is mould unsightly, but when mould spores are present in large quantities, they present a health hazard to humans. Recently, a Rochdale coroner attributed the death of a 2-year-old toddler, Awaab Ishak, to a respiratory condition caused by mould. Awaab died as a result of a severe respiratory condition due to prolonged exposure to mould in his home environment. Moulds, that are identified as toxic moulds, can produce mycotoxins that pose a serious health risk to humans and cause problems that can lead to death.
Symptoms caused by mould can include; respiratory problems, respiratory infections, allergies, asthma, red eyes, tiredness, skin rash, sinus problems, nasal blockage, frequent sneezing.
Mould And Damp To Be Given The Same Legal Standing As Gas Safety and Legionella Control
As a result of Awaab Ishak’s death, the housing ombudsman have said that the law has to be reinforced to compell housing associations and private landlords to address damp and mould problems.
This should help to prevent the deaths of children like Awaab from happening in the future.
How Can SafeSol Help With Mould?
There are effective ways of removing mould without removing the wall or surface where the mould is growing.
The most successful approach is dry fogging of an AFNOR approved biocide. SafeSol provide Huwa-San, a silver, stabilised, hydrogen peroxide at 12.5%, which is effective for this purpose. Huwa-San is AFNOR approved and will remove mould. Dry fogging produces a biocidal vapour that can access all nooks and crannies and penetrate the walls; It is not wet spraying.
Following removal of the mould and spores, the surfaces can then be treated with a biocidal coating to prevent reinfection.
Details on Huwa-San and fogging protocol can be obtained from SafeSol.
SafeSol have worked with Huwa-San technology for over 20 years and have more than 75 years experience in water treatment.
We are happy to help with any queries and provide technical support.
0191 447 8008
info@safesol.co.uk